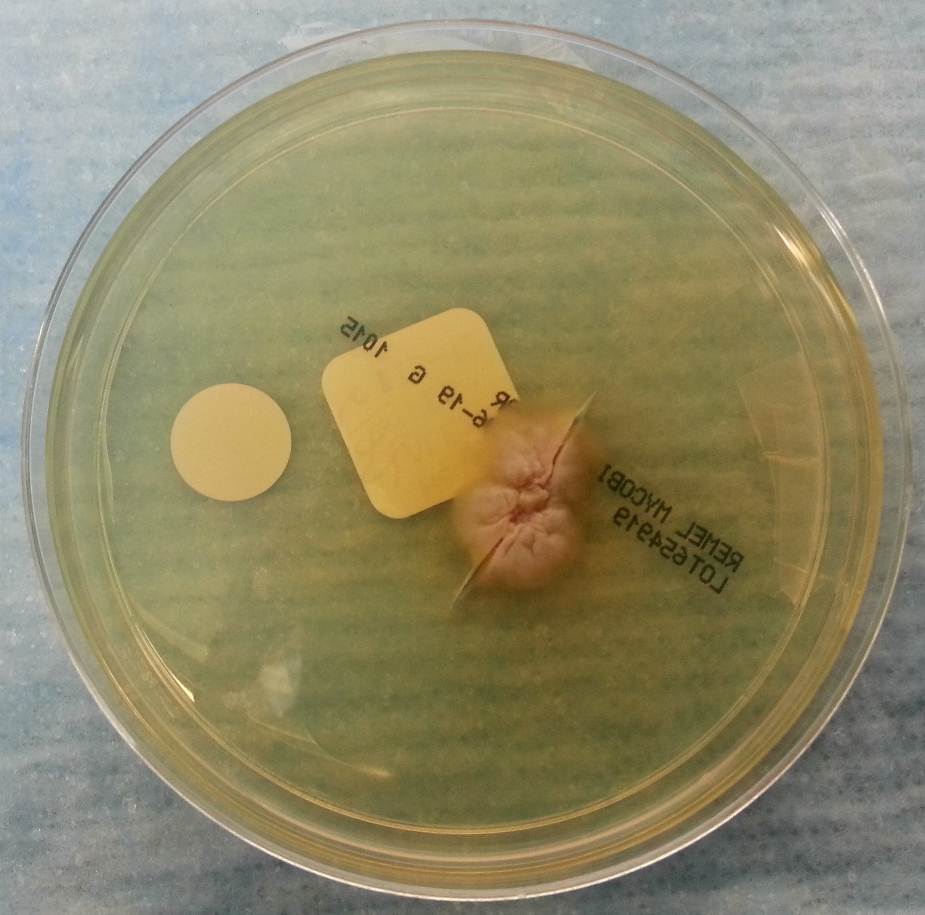

Case History:
A 76 year old female presents with a two year history of worsening upper back pain. Imaging revealed compression fractures of the first three thoracic vertebrae (T1-T3). Fine needle aspiration and a core biopsy of the T3 vertebral body were examined in surgical pathology. There was acute and chronic granulomatous inflammation with fungal organisms observed on histologic examination. Surgery for decompression and fusion of C5-T6 vertebrae was performed and tissue was sent for fungal culture.

Laboratory Identification:
The workup revealed a thermally dimorphic fungus with a mold form growing in the laboratory at 25°C and a yeast form present in the surgical pathology specimen. The mold form is moderately slow growing and has septate hyphae with small, round, terminal conidia often described as “lollipops.” The yeast form is large (8-15 microns) with broad based buds and double contoured cell walls. The immune system reacts to the presence of the fungus by forming granulomas and leads to acute and chronic inflammation within the involved tissue. The organisms can occasionally be seen within giant cells in histologic sections. The silver stain, as seen above, highlights the organisms.
Discussion:
The fungus described above exhibits the features of Blastomyces dermatitidis. This organism resides in soil and decaying plant matter and is endemic to eastern North America including the Mississippi and Ohio River Valleys as well as areas surrounding the Great Lakes and St. Lawrence River. The most common primary sites of involvement for Blastomyces are cutaneous and pulmonary. Following a primary infection, the disease can progress to disseminated blastomycosis which involves other sites such as bone.
The primary site of infection in this case is unknown. There was no history of cutaneous ulcers and chest imaging was unremarkable. The patient did have a remote history of bloody sputum production which she had attributed to “dental difficulties” that she was experiencing and has since resolved. This may have been evidence of a primary pulmonary infection preceding the vertebral involvement; however it is difficult to say with certainty.
The classic double contoured cell walls are not evident on the silver stain of the surgical pathology specimen in this case. This may be due to the fact that the bone required decalcification before histologic sections could be taken. The decalcification process may have caused an artifactual loss of the double contour. Despite the fact that this classic finding was not seen, the macroscopic and microscopic morphology is most consistent with Blastomyces.
The patient is being treated with long-term itraconazole and is currently doing well.
-Britni Bryant, MD is a 2nd year anatomic and clinical pathology resident at the University of Vermont Medical Center.
-Christi Wojewoda, MD, is the Director of Clinical Microbiology at the University of Vermont Medical Center and an Assistant Professor at the University of Vermont.



